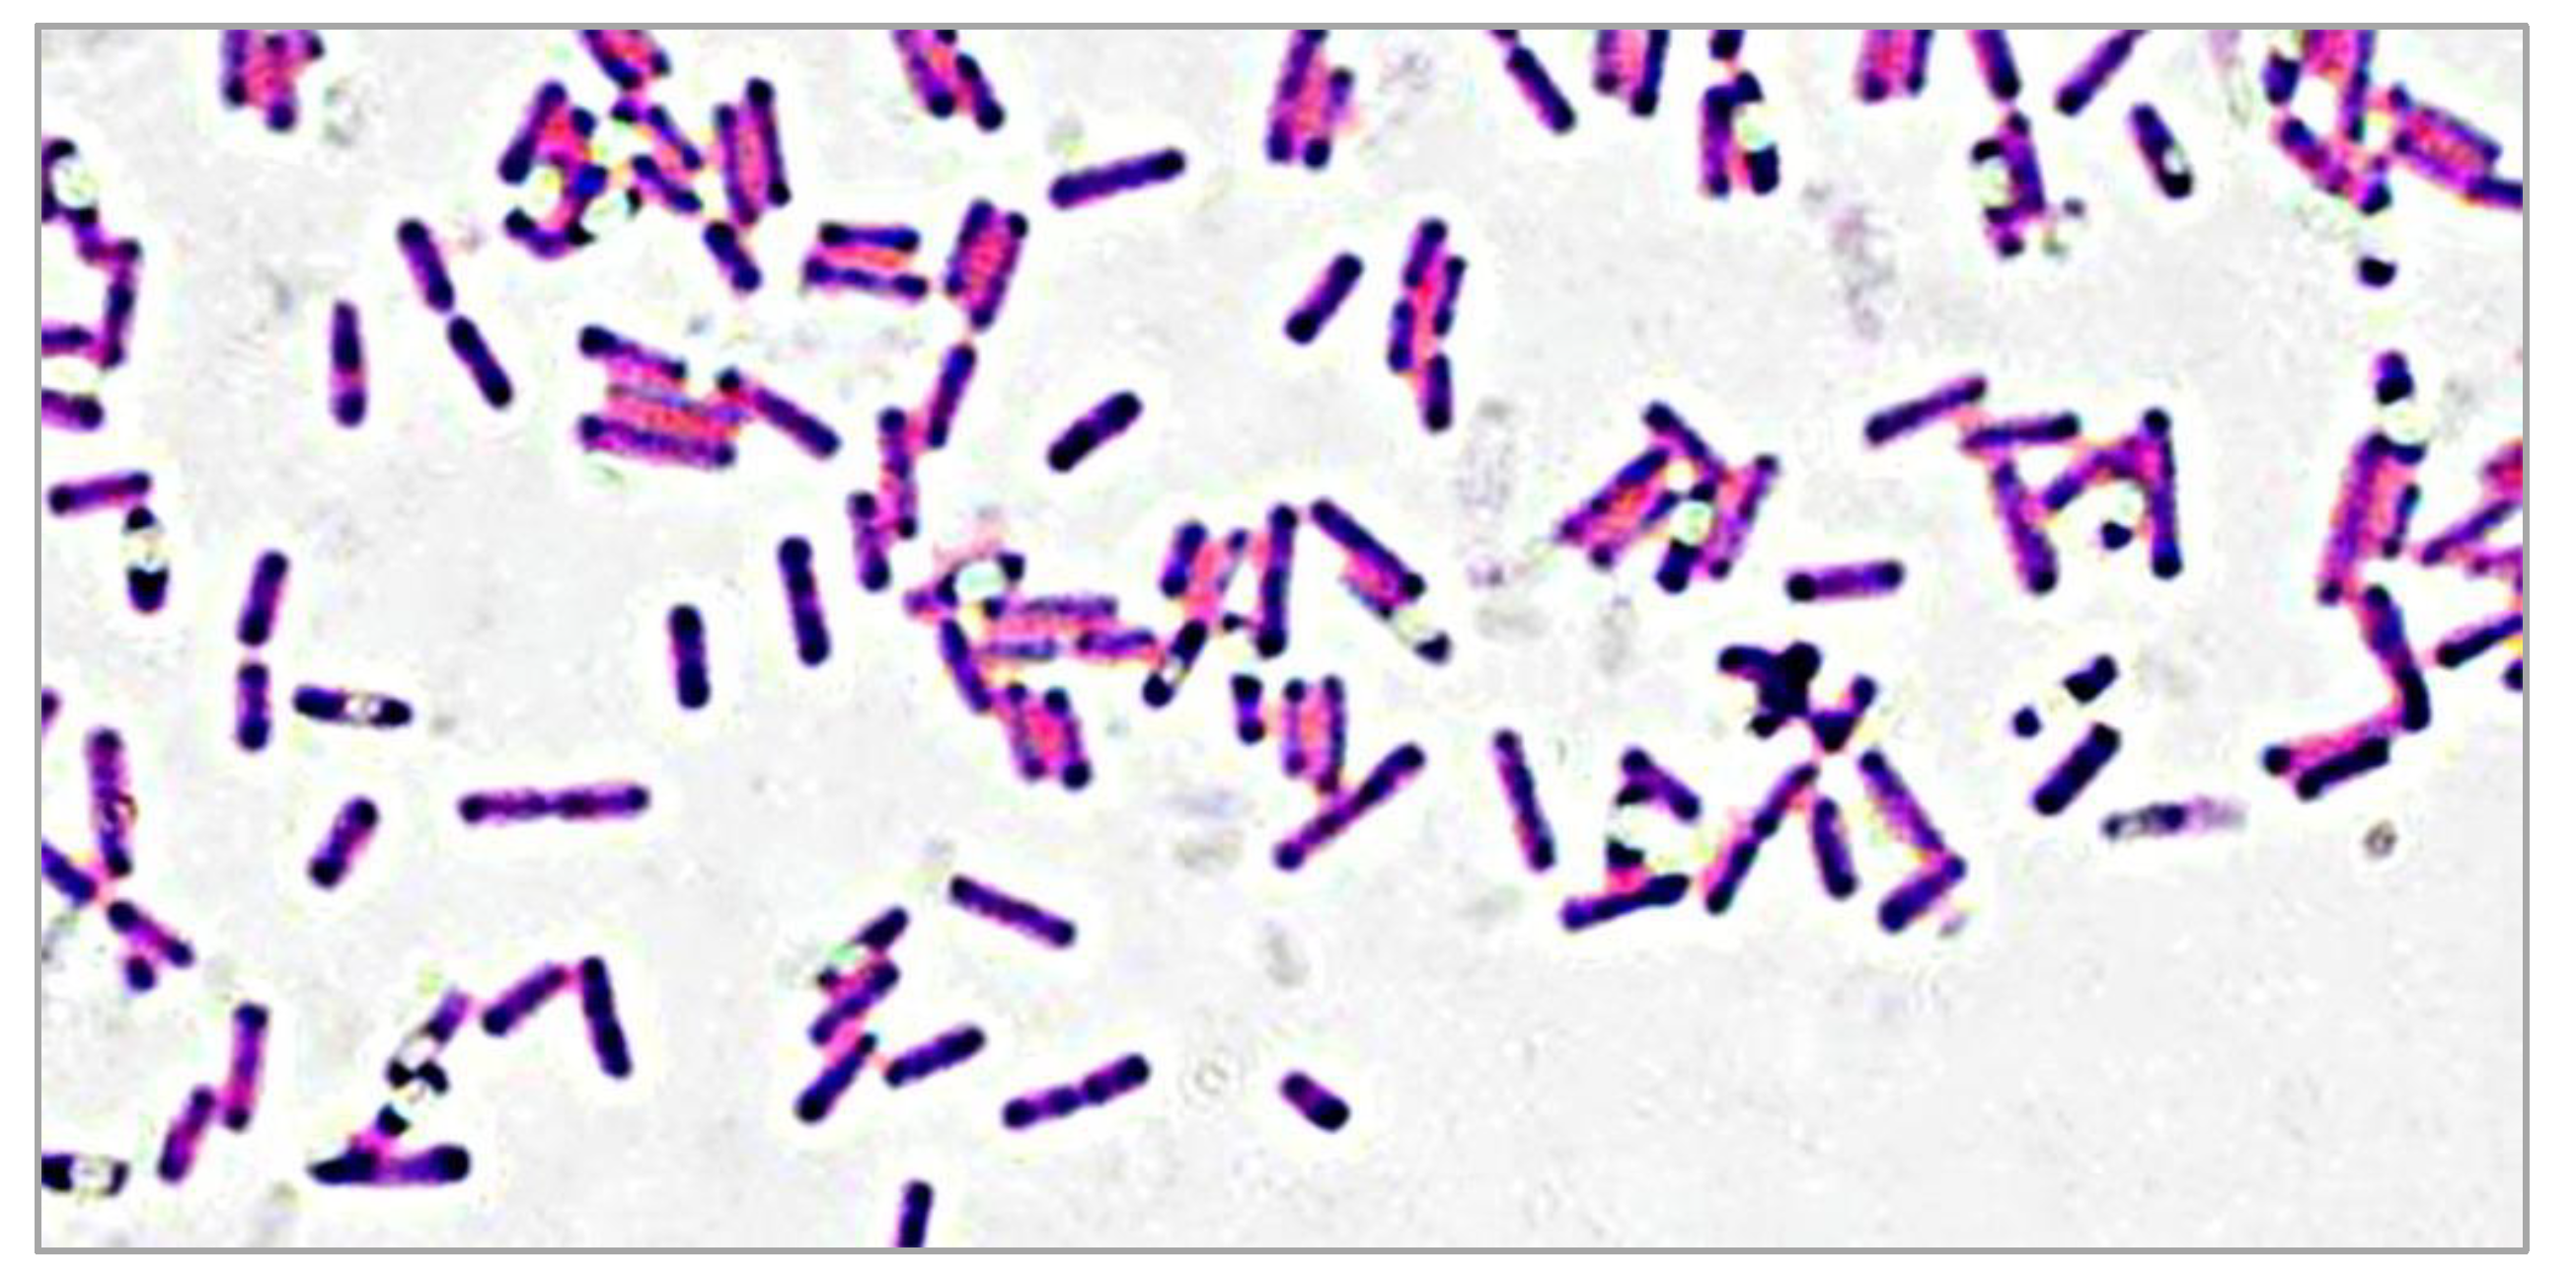
Applsci 10 04593 g003 Applsci 10 04593 g003

Isolation and Characterization of a Novel Bacterium from the Marine Environment for Trichloroacetic Acid Bioremediation
Abstract
1. Introduction
2. Materials and Methods
2.1. Sampling, Enrichments, and Growth
2.2. Preparation of Cell-Free Extracts and Dehalogenase Enzyme Assay
2.3. Biochemical and Morphological Characterization
2.4. Molecular Identification
3. Results
3.1. Growth of L. boronitolerans MH2
3.2. Enzyme Activity in Cell-Free Extracts from Cell Growth in Trichloroacetic Acid (TCA) Medium and Nutrient Broth
3.3. Morphology and Biochemical Characteristics
3.4. Polymerase Chain Reaction (PCR) Amplification of 16s rRNA Gene Analysis
3.5. Phylogeny Tree Analysis
4. Discussion
5. Conclusions
Author Contributions
Funding
Acknowledgments
Conflicts of Interest
References
- Ekambaram, P.; Narayanan, M. Upregulation of HSP70 extends Cytoprotection to fish brain under xenobiotic stress. J. FisheriesSciences.com 2017, 11, 11. [Google Scholar] [CrossRef][Green Version]
- Mishra, V.K.; Singh, G.; Shukla, R. Impact of xenobiotics under a changing climate scenario. Clim. Chang. Agric. Ecosyst. 2019, 133–151. [Google Scholar] [CrossRef]
- George, S.G. Enzymology and molecular biology of phase II xenobiotic-conjugating enzymes in fish. In Aquatic Toxicology: Molecular, Biochemical and Cellular Perspectives; Donald, C., Ed.; CRC Press: Boca Raton, FL, USA, 1994; pp. 37–85. [Google Scholar]
- Klont, F.; Jahn, S.; Grivet, C.; König, S.; Bonner, R.; Hopfgartner, G. SWATH data independent acquisition mass spectrometry for screening of xenobiotics in biological fluids: Opportunities and challenges for data processing. Talanta 2020, 211, 120747. [Google Scholar] [CrossRef] [PubMed]
- Khani, M.; Amin, N.A.S.; Hosseini, S.N.; Heidarrezaei, M. Kinetics study of the photocatalytic inactivation of Escherichia coli. Int. J. Nano Biomater. 2016, 6, 139–150. [Google Scholar] [CrossRef]
- Pehlivanoglu-Mantas, E.; Insel, G.; Karahan, O.; Cokgor, E.U.; Orhon, D. Case studies from Turkey: Xenobiotic-containing industries, wastewater treatment and modeling. Water Air Soil Pollut. Focus 2008, 8, 519–528. [Google Scholar] [CrossRef]
- Agrawal, N.; Shahi, S.K. An environmental cleanup strategy-microbial transformation of xenobiotic compounds. Int. J. Curr. Microbiol. Appl. Sci. 2015, 4, 429–461. [Google Scholar]
- Wu, R.S.S. Eutrophication, water borne pathogens and xenobiotic compounds: Environmental risks and challenges. Mar. Pollut. Bull. 1999, 39, 11–22. [Google Scholar] [CrossRef]
- George, S.; Riley, C.; McEvoy, J.; Wright, J. Development of a fish in vitro cell culture model to investigate oxidative stress and its modulation by dietary vitamin E. Mar. Environ. Res. 2000, 50, 541–544. [Google Scholar] [CrossRef]
- Johnson, G.R.; Spain, J.C. Evolution of catabolic pathways for synthetic compounds: Bacterial pathways for degradation of 2, 4-dinitrotoluene and nitrobenzene. Appl. Microbiol. Biotechnol. 2003, 62, 110–123. [Google Scholar] [CrossRef]
- Murphy, C.D. Biodegradation and biotransformation of organofluorine compounds. Biotechnol. Lett. 2010, 32, 351–359. [Google Scholar] [CrossRef]
- Kiel, M.; Engesser, K.-H. The biodegradation vs. biotransformation of fluorosubstituted aromatics. Appl. Microbiol. Biotechnol. 2015, 99, 7433–7464. [Google Scholar] [CrossRef] [PubMed]
- Barragan-Huerta, B.E.; Costa-Pérez, C.; Peralta-Cruz, J.; Barrera-Cortés, J.; Esparza-García, F.; Rodríguez-Vázquez, R. Biodegradation of organochlorine pesticides by bacteria grown in microniches of the porous structure of green bean coffee. Int. Biodeterior. Biodegrad. 2007, 59, 239–244. [Google Scholar] [CrossRef]
- Kong, L.; Zhu, S.; Zhu, L.; Xie, H.; Su, K.; Yan, T.; Wang, J.; Wang, J.; Wang, F.; Sun, F. Biodegradation of organochlorine pesticide endosulfan by bacterial strain Alcaligenes faecalis JBW4. J. Environ. Sci. 2013, 25, 2257–2264. [Google Scholar] [CrossRef]
- Waaijers, S.L.; Parsons, J.R. Biodegradation of brominated and organophosphorus flame retardants. Curr. Opin. Biotechnol. 2016, 38, 14–23. [Google Scholar] [CrossRef] [PubMed]
- Holman, H.Y.N.; Nieman, K.; Sorensen, D.L.; Miller, C.D.; Martin, M.C.; Borch, T.; McKinney, W.R.; Sims, R.C. Catalysis of PAH biodegradation by humic acid shown in synchrotron infrared studies. Environ. Sci. Technol. 2002, 36, 1276–1280. [Google Scholar] [CrossRef] [PubMed]
- Heidarrezaei, M. Degradation of Trichloroacetic Acid (TCA) by Bacteria Isolated from Marine Environment; Universiti Teknologi Malaysia: Johor, Malaysia, 2013. [Google Scholar]
- Horvath, A.L.; Getzen, F.W.; Maczynska, Z. IUPAC-NIST solubility data series 67. Halogenated ethanes and ethenes with water. J. Phys. Chem. Ref. Data 1999, 28, 395–627. [Google Scholar] [CrossRef]
- Raucy, J.L.; Kraner, J.C.; Lasker, J.M. Bioactivation of halogenated hydrocarbons by cytochrome P4502E1. Crit. Rev. Toxicol. 1993, 23, 1–20. [Google Scholar] [CrossRef]
- Wong, W.-Y.; Huyop, F. Molecular identification and characterization of Dalapon-2, 2-dichloropropionate (2, 2DCP)-degrading bacteria from a Rubber Estate Agricultural area. Afr. J. Microbiol. Res. 2012, 6, 1520–1526. [Google Scholar]
- Fetzner, S. Bacterial dehalogenation. Appl. Microbiol. Biotechnol. 1998, 50, 633–657. [Google Scholar] [CrossRef]
- van den Wijngaard, A.J.; Wind, R.D.; Janssen, D.B. Kinetics of bacterial growth on chlorinated aliphatic compounds. Appl. Environ. Microbiol. 1993, 59, 2041–2048. [Google Scholar] [CrossRef]
- Janssen, D.B.; Poelarends, G.J.; Rink, R. Engineering hydrolases for the conversion of halogenated aliphatic hydrocarbons and epoxides. In Novel Approaches for Bioremediation of Organic Pollution; Springer: Boston, MA, USA, 1999; pp. 105–116. [Google Scholar]
- Frank, H.; Scholl, H.; Renschen, D.; Rether, B.; Laouedj, A.; Norokorpi, Y. Haloacetic acids, phytotoxic secondary air pollutants. Environ. Sci. Pollut. Res. 1994, 1, 4–14. [Google Scholar] [CrossRef] [PubMed]
- Aziz, K.H.H. Application of different advanced oxidation processes for the removal of chloroacetic acids using a planar falling film reactor. Chemosphere 2019, 228, 377–383. [Google Scholar] [CrossRef] [PubMed]
- Zhang, P.; Hozalski, R.M.; Leach, L.H.; Camper, A.K.; Goslan, E.H.; Parsons, S.A.; Xie, Y.F.; LaPara, T.M. Isolation and characterization of haloacetic acid-degrading Afipia spp. from drinking water. FEMS Microbiol. Lett. 2009, 297, 203–208. [Google Scholar] [CrossRef]
- Mourão, A.O.; Silva, D.F.; Rodriguez, M.; Torres, T.S.; Franco, E.S.; Pádua, V.L.; da Silva Faria, M.C.; Maia, L.F.O.; Rodrigues, J.L. Degradation of haloacetic acids with the Fenton-like and analysis by GC-MS: Use of bioassays for monitoring of genotoxic, mutagenic and cytotoxic effects. Environ. Monit. Assess. 2019, 191, 513. [Google Scholar] [CrossRef] [PubMed]
- Ma, Y.-C.; Chiang, C.-Y. Evaluation of the effects of various gas chromatographic parameters on haloacetic acids disinfection by-products analysis. J. Chromatogr. A 2005, 1076, 216–219. [Google Scholar] [CrossRef]
- Bonner, O.D.; Prichard, P.R. The ionization of trichloroacetic acid and evidence for an unusual type of ion pairing. J. Solut. Chem. 1979, 8, 113. [Google Scholar] [CrossRef]
- Terzi, E.; Guvenc, U.; Türsen, B.; Kaya, T.İ.; Erdem, T.; Türsen, Ü. The effectiveness of matrix cauterization with trichloroacetic acid in the treatment of ingrown toenails. Indian Dermatol. Online J. 2015, 6, 4. [Google Scholar] [PubMed]
- Pereira, M.A.; Kramer, P.M.; Conran, P.B.; Tao, L. Effect of chloroform on dichloroacetic acid and trichloroacetic acid-induced hypomethylation and expression of the c-myc gene and on their promotion of liver and kidney tumors in mice. Carcinogenesis 2001, 22, 1511–1519. [Google Scholar] [CrossRef] [PubMed]
- Kadmi, Y.; Favier, L.; Ionut, S.A.; Matei, E.; Wolbert, D. Improved Determination of Dichloroacetic and Trichloroacetic Acids in Water by Solid Phase Extraction Followed by Ultra-high Performance Liquid Chromatography–Tandem Mass Spectrometry. Anal. Lett. 2016, 49, 433–443. [Google Scholar] [CrossRef]
- Pinna, M.V.; Baronti, S.; Miglietta, F.; Pusino, A. Photooxidation of foramsulfuron: Effects of char substances. J. Photochem. Photobiol. A Chem. 2016, 326, 16–20. [Google Scholar] [CrossRef]
- Oyewusi, H.A.; Wahab, R.A.; Kaya, Y.; Edbeib, M.F.; Huyop, F. Alternative bioremediation agents against haloacids, haloacetates and chlorpyrifos using novel halogen-degrading bacterial isolates from the Hypersaline Lake Tuz. Catalysts 2020, 10, 651. [Google Scholar] [CrossRef]
- Alrawas, A.A.; Huyop, F. Biodegradation of Trichloroacetic acid by Ralstonia sp.(TCAA-2) strain isolated from Danga Bay coastal area in Malaysia. J. Biotechnol. Sci. Res. 2015, 2, 103–108. [Google Scholar]
- Guengerich, F.P. Effects of nutritive factors on metabolic processes involving bioactivation and detoxication of chemicals. Annu. Rev. Nutr. 1984, 4, 207–231. [Google Scholar] [CrossRef] [PubMed]
- Ismail, S.N.F.; Wahab, R.A.; Huyop, F. Microbial isolation and degradation of selected haloalkanoic aliphatic acids by locally isolated bacteria: A review. Malays. J. Microbiol. 2017, 13, 261–272. [Google Scholar]
- Slater, J.H. Microbial dehalogenation of haloaliphatic compounds. In Biochemistry of Microbial Degradation; Springer: Dordrecht, The Netherlands, 1994; pp. 379–421. [Google Scholar]
- Satpathy, R.; Konkimalla, V.B.; Ratha, J. In silico phylogenetic analysis and molecular modelling study of 2-haloalkanoic acid dehalogenase enzymes from bacterial and fungal origin. Adv. Bioinform. 2016, 2016. [Google Scholar] [CrossRef][Green Version]
- Fabritz, S.; Maaß, F.; Avrutina, O.; Heiseler, T.; Steinmann, B.; Kolmar, H. A sensitive method for rapid detection of alkyl halides and dehalogenase activity using a multistep enzyme assay. AMB Express 2012, 2, 51. [Google Scholar] [CrossRef]
- Harvey, S.P. Enzymatic Degradation of HD; U.S. Army Edgewood Chemical Biological Center (ECBC): Gunpower, MD, USA, 2001. [Google Scholar]
- Muslem, W.H.; Edbeib, M.F.; Aksoy, H.M.; Kaya, Y.; Hamid, A.A.A.; Hood, M.H.M.; Wahab, R.A.; Huyop, F. Biodegradation of 3-chloropropionic acid (3-CP) by Bacillus cereus WH2 and its in silico enzyme-substrate docking analysis. J. Biomol. Struct. Dyn. 2019, 1–10. [Google Scholar] [CrossRef]
- Hamid, A.A.A.; Tengku Abdul Hamid, T.H.; Wahab, R.A.; Huyop, F. Identification of functional residues essential for dehalogenation by the non-stereospecific α-haloalkanoic acid dehalogenase from Rhizobium sp. RC1. J. Basic Microbiol. 2015, 55, 324–330. [Google Scholar] [CrossRef]
- Adamu, A.; Wahab, R.A.; Aliyu, F.; Aminu, A.H.; Hamza, M.M.; Huyop, F. Haloacid dehalogenases of Rhizobium sp. and related enzymes: Catalytic properties and mechanistic analysis. Process Biochem. 2020, 92, 437–446. [Google Scholar] [CrossRef]
- Selvamani, S.; Ab Wahab, R.; Huyop, F. A novel putative non-ligninolytic dehalogenase activity for 3-chloropropionic acid (3CP) utilization by Trichoderma asperellum strain SD1. Malays. J. Microbiol. 2015, 11, 265–272. [Google Scholar] [CrossRef][Green Version]
- Bagherbaigi, S.; Gicana, R.G.; Lamis, R.J.; Nemati, M.; Huyop, F. Characterisation of Arthrobacter sp. S1 that can degrade α and β-haloalkanoic acids isolated from contaminated soil. Ann. Microbiol. 2013, 63, 1363–1369. [Google Scholar] [CrossRef]
- Hareland, W.A.; Crawford, R.L.; Chapman, P.J.; Dagley, S. Metabolic function and properties of 4-hydroxyphenylacetic acid 1-hydroxylase from Pseudomonas acidovorans. J. Bacteriol. 1975, 121, 272–285. [Google Scholar] [CrossRef] [PubMed]
- Leisinger, T.; Bader, R. Microbial dehalogenation of synthetic organohalogen compounds: Hydrolytic dehalogenases. Chim. Int. J. Chem. 1993, 47, 116–121. [Google Scholar]
- Bhatt, P.; Kumar, M.S.; Mudliar, S.; Chakrabarti, T. Biodegradation of chlorinated compounds—A review. Crit. Rev. Environ. Sci. Technol. 2007, 37, 165–198. [Google Scholar] [CrossRef]
- Slater, J.H.; Bull, A.T.; Hardman, D.J. Microbial dehalogenation. Biodegradation 1995, 6, 181–189. [Google Scholar] [CrossRef]
- Slater, J.H.; Bull, A.T.; Hardman, D.J. Microbial dehalogenation of halogenated alkanoic acids, alcohols and alkanes. Adv. Microb. Physiol. 1996, 38, 133–176. [Google Scholar]
- Nichele, L.; Persichetti, V.; Lucidi, M.; Cincotti, G. Quantitative evaluation of ImageJ thresholding algorithms for microbial cell counting. OSA Contin. 2020, 3, 1417–1427. [Google Scholar] [CrossRef]
- Salim, A.A.; Bidin, N.; Lafi, A.S.; Huyop, F.Z. Antibacterial activity of PLAL synthesized nanocinnamon. Mater. Des. 2017, 132, 486–495. [Google Scholar] [CrossRef]
- Mesri, S.; Wahab, R.A.; Huyop, F. Degradation of 3-chloropropionic acid (3CP) by Pseudomonas sp. B6P isolated from a rice paddy field. Ann. Microbiol. 2009, 59, 447–451. [Google Scholar] [CrossRef]
- Cappuccino, J.G.; Sherman, N. Microbiology: A Laboratory Manual; Pearson/Benjamin Cummings: San Francisco, CA, USA, 2005. [Google Scholar]
- Holt, J.G.; Krieg, N.R.; Sneath, P.H.A. Bergey’s Manual of Determinative Bacterology; Springer: New York, NY, USA, 1994. [Google Scholar]
- Reddy, N.G.; Ramakrishna, D.P.N.; Raja Gopal, S.V. A morphological, physiological and biochemical studies of marine Streptomyces rochei (MTCC 10109) showing antagonistic activity against selective human pathogenic microorganisms. Asian J. Biol. Sci. 2011, 4, 1–14. [Google Scholar] [CrossRef][Green Version]
- Fulton, C.K.; Cooper, R.A. Catabolism of sulfamate by Mycobacterium sp. CF1. Environ. Microbiol. 2005, 7, 378–381. [Google Scholar] [CrossRef] [PubMed]
- Tamura, K.; Peterson, D.; Peterson, N.; Stecher, G.; Nei, M.; Kumar, S. MEGA5: Molecular evolutionary genetics analysis using maximum likelihood, evolutionary distance, and maximum parsimony methods. Mol. Biol. Evol. 2011, 28, 2731–2739. [Google Scholar] [CrossRef] [PubMed]
- Saitou, N.; Nei, M. The neighbor-joining method: A new method for reconstructing phylogenetic trees. Mol. Biol. Evol. 1987, 4, 406–425. [Google Scholar] [PubMed]
- Bergmann, J.G.; Sanik, J. Determination of trace amounts of chlorine in naphtha. Anal. Chem. 1957, 29, 241–243. [Google Scholar] [CrossRef]
- Horisaki, T.; Yoshida, E.; Sumiya, K.; Takemura, T.; Yamane, H.; Nojiri, H. Isolation and characterization of monochloroacetic acid-degrading bacteria. J. Gen. Appl. Microbiol. 2011, 57, 277–284. [Google Scholar] [CrossRef][Green Version]
- Zulkifly, A.H.; Roslan, D.D.; Hamid, A.A.A.; Hamdan, S.; Huyop, F. Biodegradation of low concentration of monochloroacetic acid-degrading bacillus sp. TW 1 Isolated from Terengganu Water Treatment and Distribution Plant. J. Appl. Sci. 2010, 10, 2940–2944. [Google Scholar]
- Vasileva, E.; Petrov, K.; Beschkov, V. Fed batch strategy for biodegradation of monochloroacetic acid by immobilized Xantobacter autotrophicus GJ10 in polyacrylamide gel. C. R. L’Academie Bulg. Des. Sci. 2009, 62, 1241–1246. [Google Scholar]
- Vasileva, E.; Petrov, K.; Beschkov, V. Biodegradation of monochloroacetic acid by immobilization of xanthobacter autotrophicus gj10 in polyacrylamide gel. Biotechnol. Biotechnol. Equip. 2009, 23, 788–790. [Google Scholar] [CrossRef]
- Ismail, S.N.; Taha, A.M.; Jing, N.H.; Wahab, R.A.; Hamid, A.A.; Pakingking, R.V., Jr.; Huyop, F. Biodegradation of monochloroacetic acid by a presumptive Pseudomonas sp. strain R1 bacterium isolated from Malaysian paddy (Rice) field. Biotechnology 2008, 7, 481–486. [Google Scholar] [CrossRef]
- Meusel, M.; Rehm, H.-J. Biodegradation of dichloroacetic acid by freely suspended and adsorptive immobilized Xanthobacter autotrophicus GJ10 in soil. Appl. Microbiol. Biotechnol. 1993, 40, 165–171. [Google Scholar] [CrossRef]
- Pang, B.C.M.; Tsang, J.S.H. Mutagenic analysis of the conserved residues in dehalogenase IVa of Burkholderia cepacia MBA4. FEMS Microbiol. Lett. 2001, 204, 135–140. [Google Scholar] [CrossRef] [PubMed]
- Weightman, A.L.; Weightman, A.J.; Slater, J.H. Microbial dehalogenation of trichloroacetic acid. World J. Microbiol. Biotechnol. 1992, 8, 512–518. [Google Scholar] [CrossRef] [PubMed]
- Jayasuriya, G.C.N. The isolation and characteristics of an oxalate-decomposing organism. Microbiology 1955, 12, 419–428. [Google Scholar] [CrossRef] [PubMed]

| Composition | Proportion | Composition | Name | Formula | Reference |
|---|---|---|---|---|---|
| Basal salts | 10 mL | 42.5 g∙L−1 | Dipotassium hydrogen phosphate 3-hydrate | K2HPO4∙3H2O | Hareland et al. [47] |
| 10 g∙L−1 | Sodium dihydrogen phosphate 2-hydrate | NaH2 PO4∙2(H2O) | |||
| 25 g∙L−1 | Ammonium sulfate | (NH4)2 SO4 | |||
| Trace metals solution | 10 mL | 1.0 g∙L−1 | Nitrilotriacetic acid | N(CH2COOH)3 | Hareland et al. [47] |
| 2.0 g∙L−1 | Magnesium sulphate | MgSO4 | |||
| 0.12 g∙L−1 | Iron sulphateheptahydrate | FeSO4∙7H2O | |||
| 0.03 g∙L−1 | Magan sulfate heptahydrate | MnSO4∙7H2O | |||
| 0.03 g∙L−1 | Zinc sulphate monohydrate | ZnSO4∙H2O | |||
| 0.01 g∙L−1 | Cobalt chlorine hexahydrate | CoCl2∙6H2O | |||
| TCA | 1 mL | 10 mM | Trichloroacetic acid | C2HCl3O2 | Fisher Scientific |
| Distilled water | 79 mL | - | Distilled water | H2O | - |
| Total volume | 100 mL | - | - | - | - |
| Objective | Test | Composition and Materials | Incubation Condition | Aim | Description | Reference |
|---|---|---|---|---|---|---|
| Characterization of bacteria | Gram staining |
| - | To determine the type of bacteria (Gram-positive or gram-negative) | Smear color | [55] |
| Spore staining |
| - | To determine the spore production of bacterium | Retaining cell color | ||
| Motility |
| Incubated at 30–37 °C for 24–48 h. | To determine the motility and to explore the capability of bacteria to migrate away from a line of inoculation | Turbidity diffusion from the stab line | ||
| Biochemical tests | Catalase |
| - | To differentiate aerobic and obligate anaerobic bacteria | Bubble formation | [56,57] |
| Oxidase |
| - | To determine the taxonomic status and identity of pathogenic bacteria | Color change | ||
| Urease |
| Autoclaved at 121 °C for 20 min. Incubated at 37 °C 24–48 h. | To determine the ability of bacteria to decompose urea which produces the enzyme urease | Color change | ||
| Gelatin Liquefaction |
| Incubated at 33 °C for four days | To explore the ability of an organism to produce extracellular proteolytic enzyme | Solidification and hydrolysis of gelatin | ||
| Citrate |
| Autoclaved at 121 °C for 20 min. Incubated at 37 °C for 24–48 h. | To look at the ability of enteric organisms based on the ability to ferment citrate as a carbon source | Color change | ||
| MacConkey Agar |
| Autoclaved at 121 °C for 20 min. Incubated at 37 °C for 24–48 h. | To isolate Gram-negative enteric bacteria and the differentiation of lactose fermenting from lactose non- fermenting Gram-negative bacteria | Colony observation | ||
| Casein hydrolysis |
| Incubated at 33 °C for three days | To identify bacteria capable of hydrolyzing casein with casease enzyme. | Observation of clear zone | ||
| Starch |
| Autoclaved at 121 °C for 20 min. Incubated at 37 °C. for 24–48 h | To determine the amylase enzyme with the ability to degrade starch | Color formation | ||
| Indole |
| Autoclaved at 121 °C for 20 min at pH 7.5 | Tryptophanase enzyme | Color formation | ||
| Triple Sugar Iron (TSI) |
| Autoclaved at 121 °C for 20 min; incubate for 24–72 h | To test a microorganism’s ability to ferment sugars and to produce acid | Color formation |
| Step | Temperature | Time | Cycles |
|---|---|---|---|
| Initial | 94 °C | 5 min | 1 |
| Denaturation | |||
| Denaturation | 94 °C | 1 min | 30 |
| Annealing | 55 °C | 1 min | |
| Elongation | 72 °C | 4 min | |
| Final Elongation | 72 °C | 10 min | 1 |
| Characteristic | Parameter |
|---|---|
| Identity | L. boronitolerans MH2 |
| Cell shape | Rod shape |
| Size | 0.5~1 mm |
| Colony | Cream |
| O2 requirement | Aerobic |
| Colony morphology | Smooth, mucoid, a little elevated |
| Test | Spore Forming | Gram Staining | Motility | Catalase | Oxidase | Urease | Gelatin | Citrate | MacConkey Agar | Casein Hydrolysis | Starch | Indole | TSI |
|---|---|---|---|---|---|---|---|---|---|---|---|---|---|
| Result | + | + | + | − | + | + | − | − | − | + | + | − | − |
© 2020 by the authors. Licensee MDPI, Basel, Switzerland. This article is an open access article distributed under the terms and conditions of the Creative Commons Attribution (CC BY) license (http://creativecommons.org/licenses/by/4.0/).
Share and Cite
Heidarrezaei, M.; Shokravi, H.; Huyop, F.; Rahimian Koloor, S.S.; Petrů, M. Isolation and Characterization of a Novel Bacterium from the Marine Environment for Trichloroacetic Acid Bioremediation. Appl. Sci. 2020, 10, 4593. https://doi.org/10.3390/app10134593
Heidarrezaei M, Shokravi H, Huyop F, Rahimian Koloor SS, Petrů M. Isolation and Characterization of a Novel Bacterium from the Marine Environment for Trichloroacetic Acid Bioremediation. Applied Sciences. 2020; 10(13):4593. https://doi.org/10.3390/app10134593
Chicago/Turabian StyleHeidarrezaei, Mahshid, Hoofar Shokravi, Fahrul Huyop, Seyed Saeid Rahimian Koloor, and Michal Petrů. 2020. "Isolation and Characterization of a Novel Bacterium from the Marine Environment for Trichloroacetic Acid Bioremediation" Applied Sciences 10, no. 13: 4593. https://doi.org/10.3390/app10134593
APA StyleHeidarrezaei, M., Shokravi, H., Huyop, F., Rahimian Koloor, S. S., & Petrů, M. (2020). Isolation and Characterization of a Novel Bacterium from the Marine Environment for Trichloroacetic Acid Bioremediation. Applied Sciences, 10(13), 4593. https://doi.org/10.3390/app10134593

